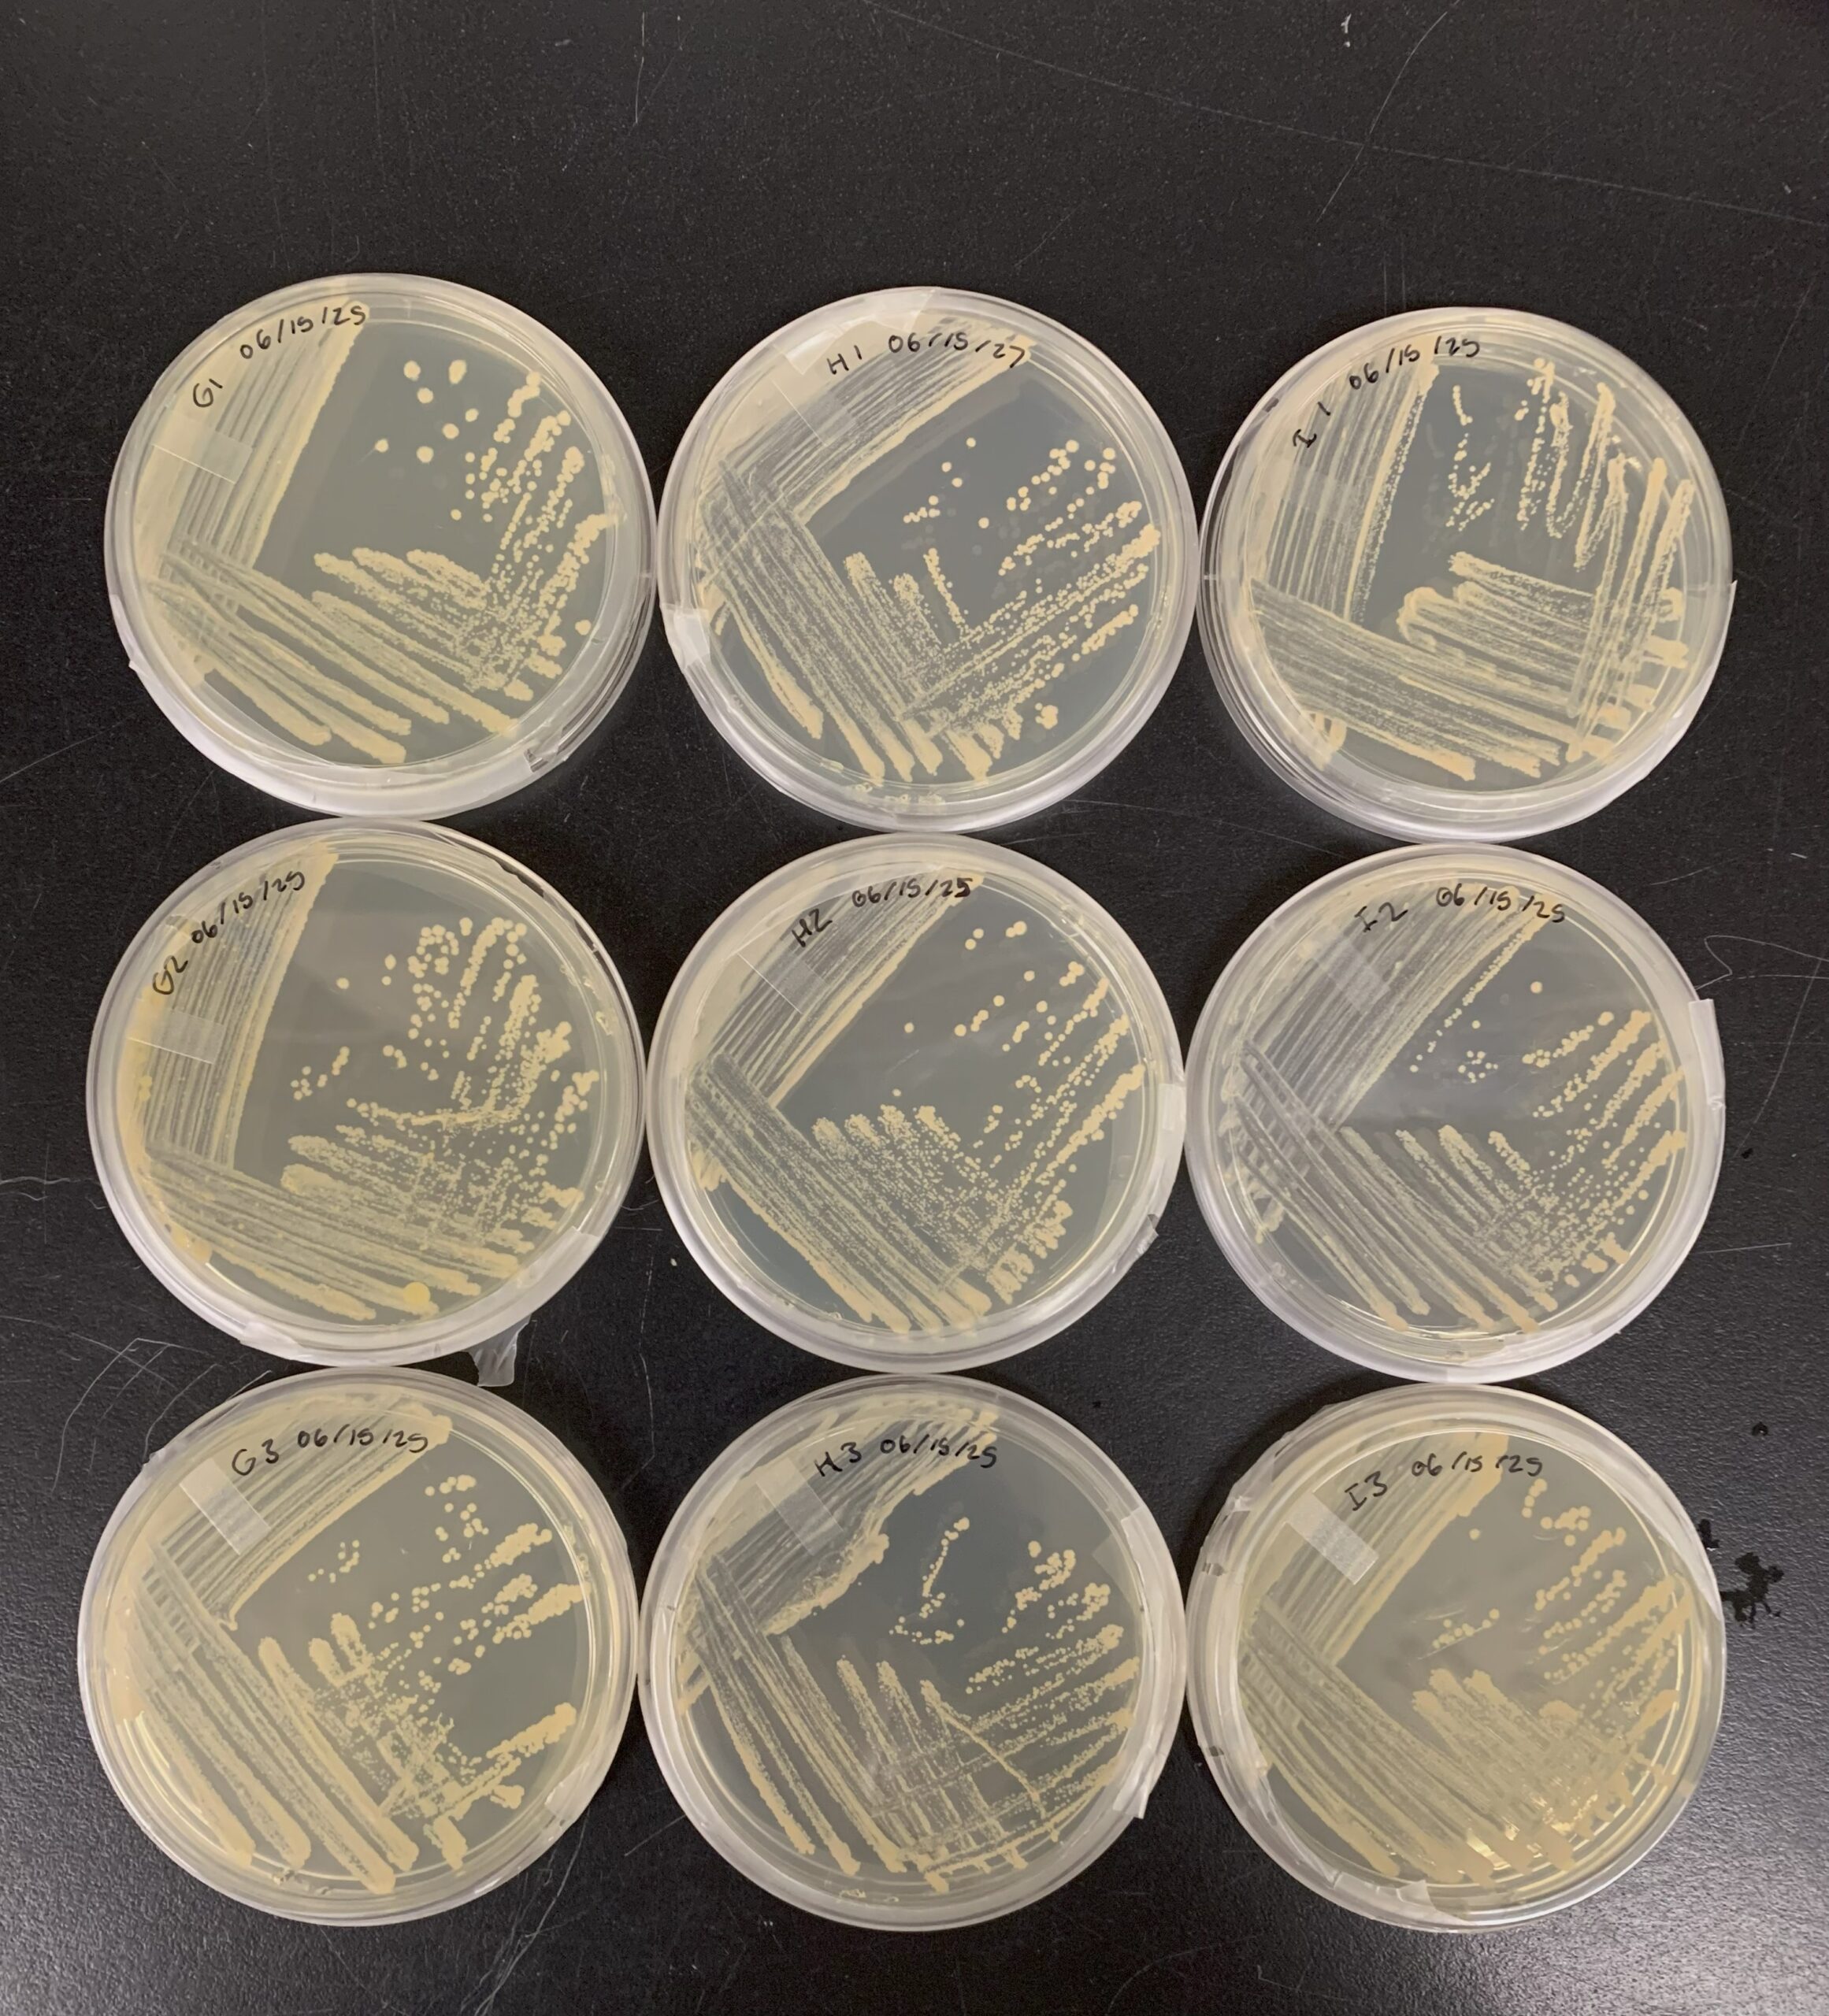

Honours Proposal – Fall 2025
Currently working on an honours project with Dr. Jonathan Van Hamme and Dr. Sharon Brewer to provide further insight into PFAS metabolism by NB4-1Y. The project involves quantification of mRNA levels of putative desulfonation genes over time using chip digital PCR (dPCR) when NB4-1Y is provided with various sulfur sources. The results from the project will be compiled into a thesis and defended by Summer 2026.
NSERC USRA – Summer 2025
Continued my work in collaboration with Dr. Jonathan Van Hamme to investigate the ability of Gordonia sp. strain NB4-1Y to degrade environmentally concerning perfluoroalkyl and polyfluoroalkyl substances (PFAS). This involved conducting a time course experiment with the end goal of measuring gene expression over time when NB4-1Y is provided with various sulfur sources including PFAS. I was able to collect data and refine methodologies that will be included in my honours thesis.
Directed Study Proposal – Winter 2025
Collaborated with supervisor Dr. Jonathan Van Hamme and co-supervisor Dr. Eric Bottos to develop a method to quantify the expression levels for six genes of interest using reverse transcriptase quantitative digital polymerase chain reaction (dPCR). The assays were tested and validated using a combination of end-point PCR and Sanger sequencing. The resulting data was analyzed and presented both locally and nationally.
Introduction to Research – Winter 2025
This seminar enables students to focus on creating research hypotheses and producing a research proposal, in preparation for their application to do an Honours or Directed Study research project. This course taught me the importance of the scientific method and the significant planning that goes into an individual research project.
Research Assistant – Fall 2024
Worked with Dr. Jonathan Van Hamme to find an anaerobic bacteria that was capable of PFAS degradation. Learned many anaerobic microbiology techniques and followed analytical procedures for optical density and fluoride ion release data collection.
NSERC USRA – Summer 2024
Continued my work with Dr. Jonathan Van Hamme regarding PFAS degrading bacteria, specifically NB4-1Y and JVH1. The work involved many independently organized time course experiments where these PFAS degrading bacteria were grown using various sulphur sources. The methods developed were used later during my directed study and honours project. Additionally, I sequenced the complete genome for Rhodococcus sp. JVH1 and published on the National Centre for Biotechnology Information database.
Research Assistant – Summer 2023
Began my research journey by working as a research assistant with Dr. Jonathan Van Hamme and Dr. Eric Bottos. Developed a method for extracting DNA from difficult to lyse bacteria, NB4-1Y, and for sequencing bacterial genomes using Nanopore sequencing technology. The developed method was used the following summer to sequence the genome for another bacteria, Rhodococcus sp. JVH1.
